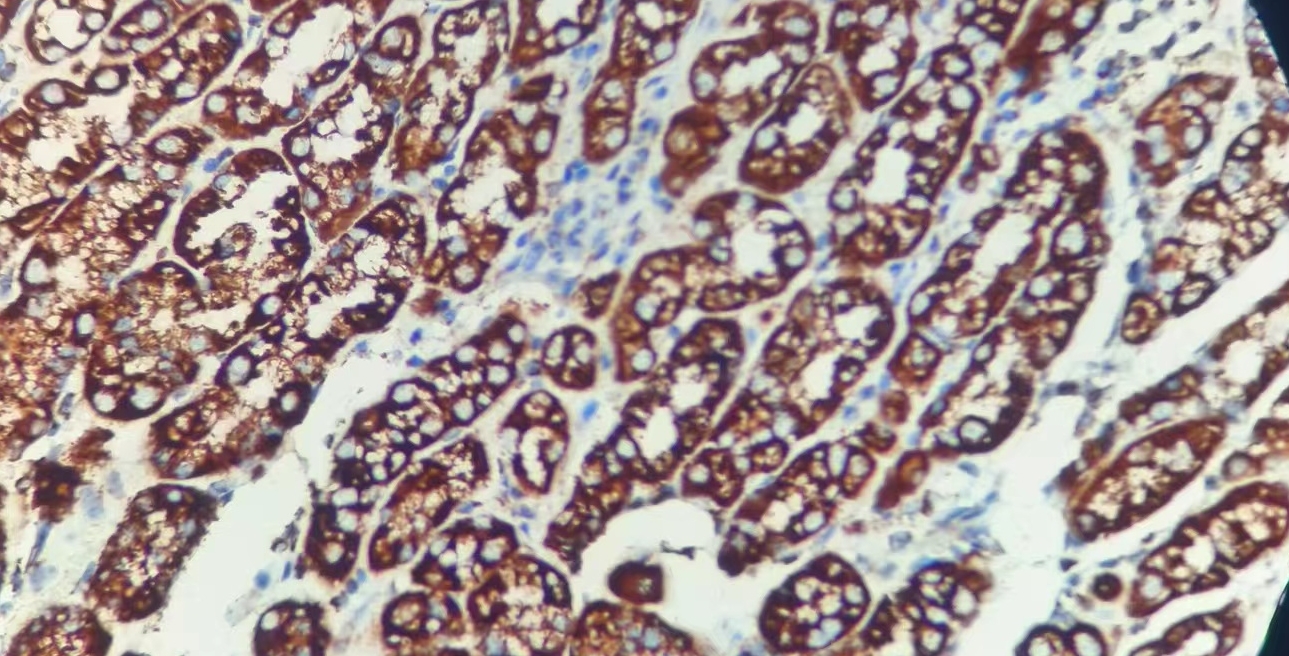

SDHB抗体试剂
SDHB抗体试剂
琥珀酸脱氢酶复合体B亚基
产品描述
SDHB抗体是一种用于检测琥珀酸脱氢酶复合体铁硫亚基(SDHB)的小鼠单克隆抗体,该蛋白由核基因编码并定位于线粒体内膜,其突变与遗传性副神经节瘤综合征(表现为嗜铬细胞瘤和副神经节瘤)、Carney-Stratakis综合征相关胃肠道间质瘤(GIST)等多种肿瘤密切相关。该抗体在病理诊断中具有独特价值:所有SDHx基因(包括SDHB/SDHC/SDHD)突变的副神经节瘤均呈现SDHB蛋白表达缺失(免疫组化阴性),而上皮样细胞型GIST若显示SDHB阴性则提示可能存在SDHx突变(与KIT/PDGFRA突变型GIST不同)。作为可靠的筛查工具,SDHB免疫组化检测不仅能识别SDHx突变相关肿瘤,还可为Carney三联征等罕见综合征的分子诊断提供重要依据。
参考文献
产品信息
备案名称:
琥珀酸脱氢酶复合体B亚基(SDHB)抗体试剂
备案证号:
粤深械备 20221642
产品型号:
DMRD0259
适用:
阳性部位:
细胞质
预 处 理:
产品规格
| 类型 | 即用型 | 浓缩型 | ||||
| 规格 | 1ml | 3ml | 6ml | 10ml | 0.1ml | 0.2ml |


